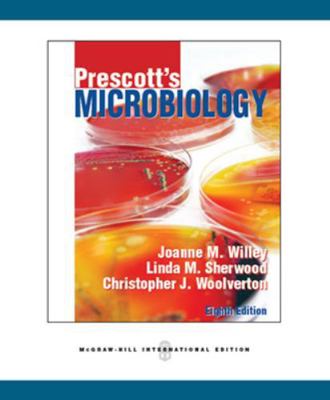
Prescott's Microbiology B00BG7JB9C Book Cover

Prescott's Microbiology 10th edition provides a balance, comprehensive introduction to all major areas of microbiology. This balance makes Microbiology appropriate for microbiology majors and mixed majors courses. The authors have introduced a number of pedagogical elements designed...







The author team of Prescott's Microbiology continues the tradition of past editions by providing a balanced, comprehensive introduction to all major areas of microbiology. This balance makes Microbiology appropriate for microbiology majors and mixed majors courses. The authors...




Connect is the only integrated learning system that empowers students by continuously adapting to deliver precisely what they need, when they need it, how they need it, so that your class time is more engaging and effective. The author team of Prescott's Microbiology continues...

Connect is the only integrated learning system that empowers students by continuously adapting to deliver precisely what they need, when they need it, how they need it, so that your class time is more engaging and effective. The author team of Prescott's Microbiology continues...


